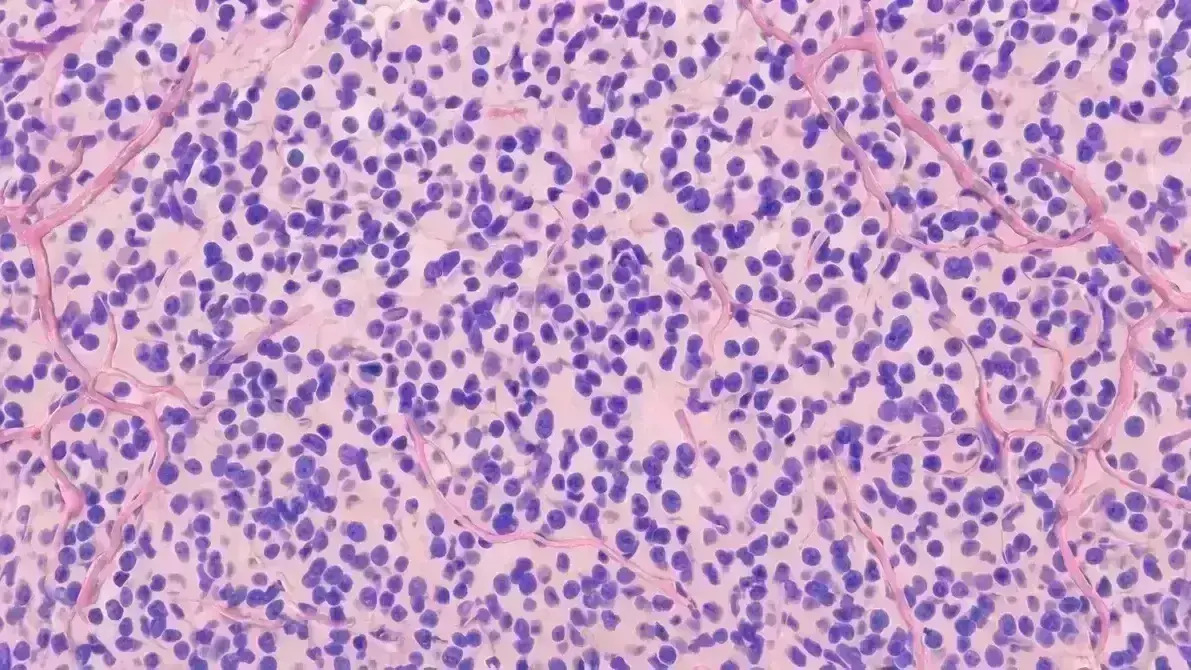
🧠 Oligodendroglioma Anaplásico Grau 3

🧠 Oligodendroglioma Anaplásico Grau 3
Sinônimos: Oligodendroglioma maligno, Tumor glial de alto grau, "Ovo frito agressivo"
> "É como o irmão mais agressivo do tumor de baixo grau — as células que parecem ovos fritos sob o microscópio começam a se dividir rapidamente, tomando conta do cérebro mais depressa. Ainda mantém a assinatura molecular 1p/19q, mas o comportamento é mais voraz."
⚡ Sintomas
- 🤕 Dor de cabeça intensa e progressiva (piora em semanas)
- 💪 Fraqueza progressiva (um lado do corpo)
- 🧠 Confusão mental e alteração de comportamento
- ⚡ Convulsões de difícil controle
- 🤢 Náuseas e vômitos (pressão intracraniana)
🧠 O que é?
Tumor cerebral maligno (Grau 3) originado dos oligodendrócitos (células que produzem mielina). Diferente do Grau 2 pela alta taxa de divisão celular (mitoses). Caracteriza-se pela codeleção 1p/19q (marcador molecular que o torna sensível à quimioterapia PCV, diferente de astrocitomas).
💊 Tratamento
- 🔪 Cirurgia (ressecção máxima possível)
- ☢️ Radioterapia (60 Gy — dose alta)
- 🧪 Quimioterapia PCV (procarbazina, lomustina, vincristina — padrão ouro)
- 💊 Temozolomida (alternativa)
- 💊 Corticoides (dexametasona — controlar edema)
⚠️ Cuidados essenciais
- 🧬 Confirmação molecular 1p/19q e IDH (essencial para diagnóstico correto)
- 📊 RM a cada 3 meses no primeiro ano (vigilância de recidiva)
- 🩸 Monitorar plaquetas (quimioterapia mielossupressora)
- 🧠 Controle de convulsões rigoroso
- 💪 Reabilitação neurológica precoce